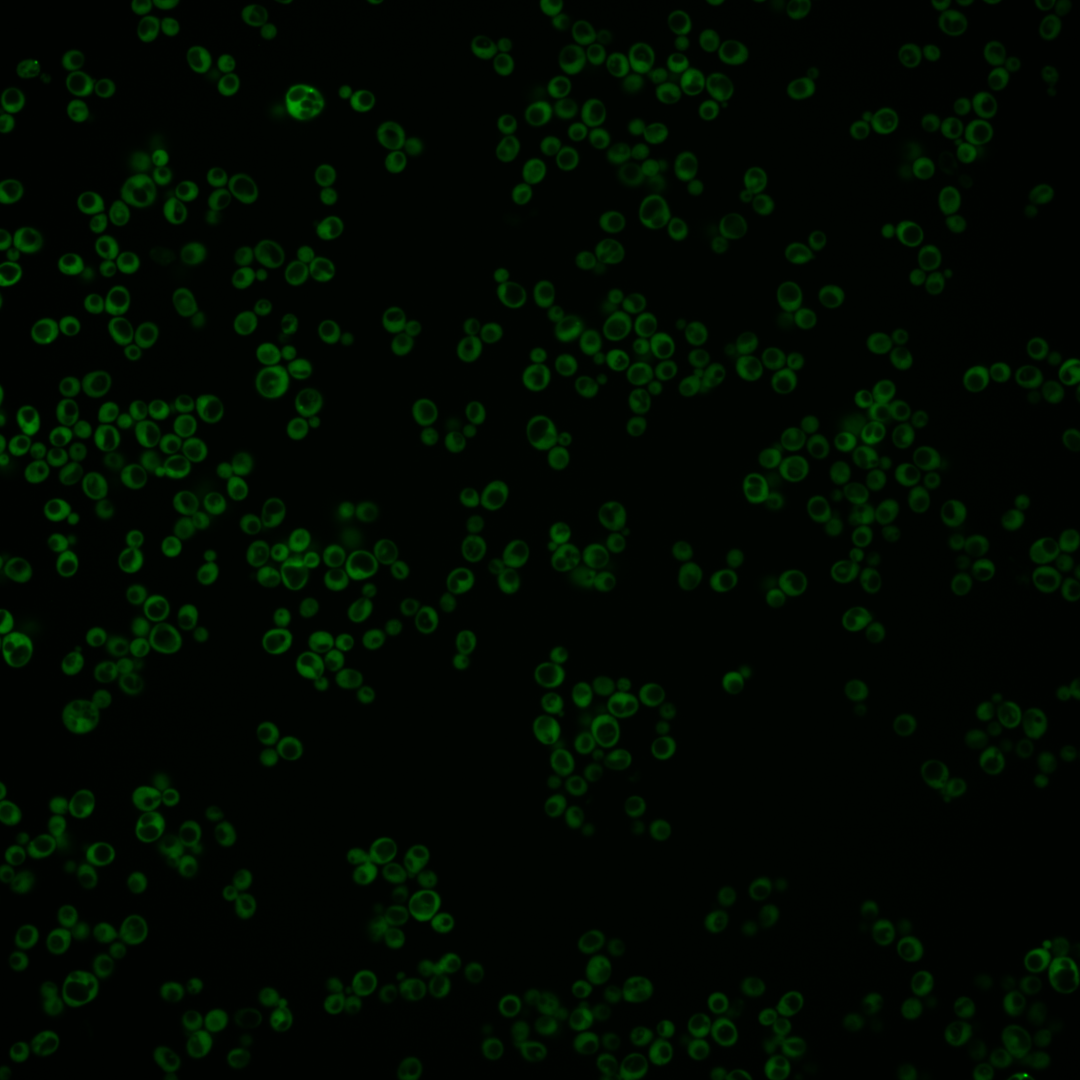
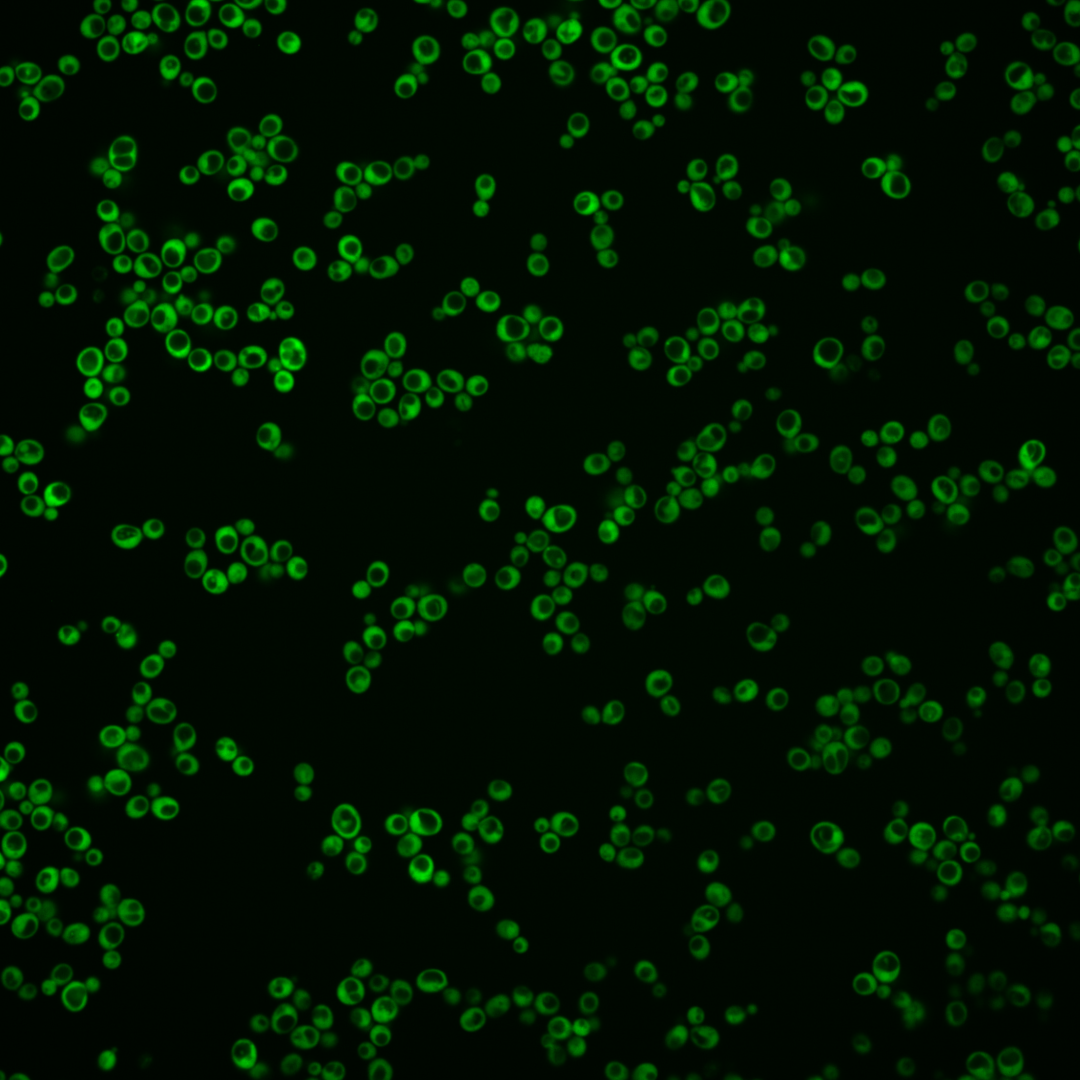
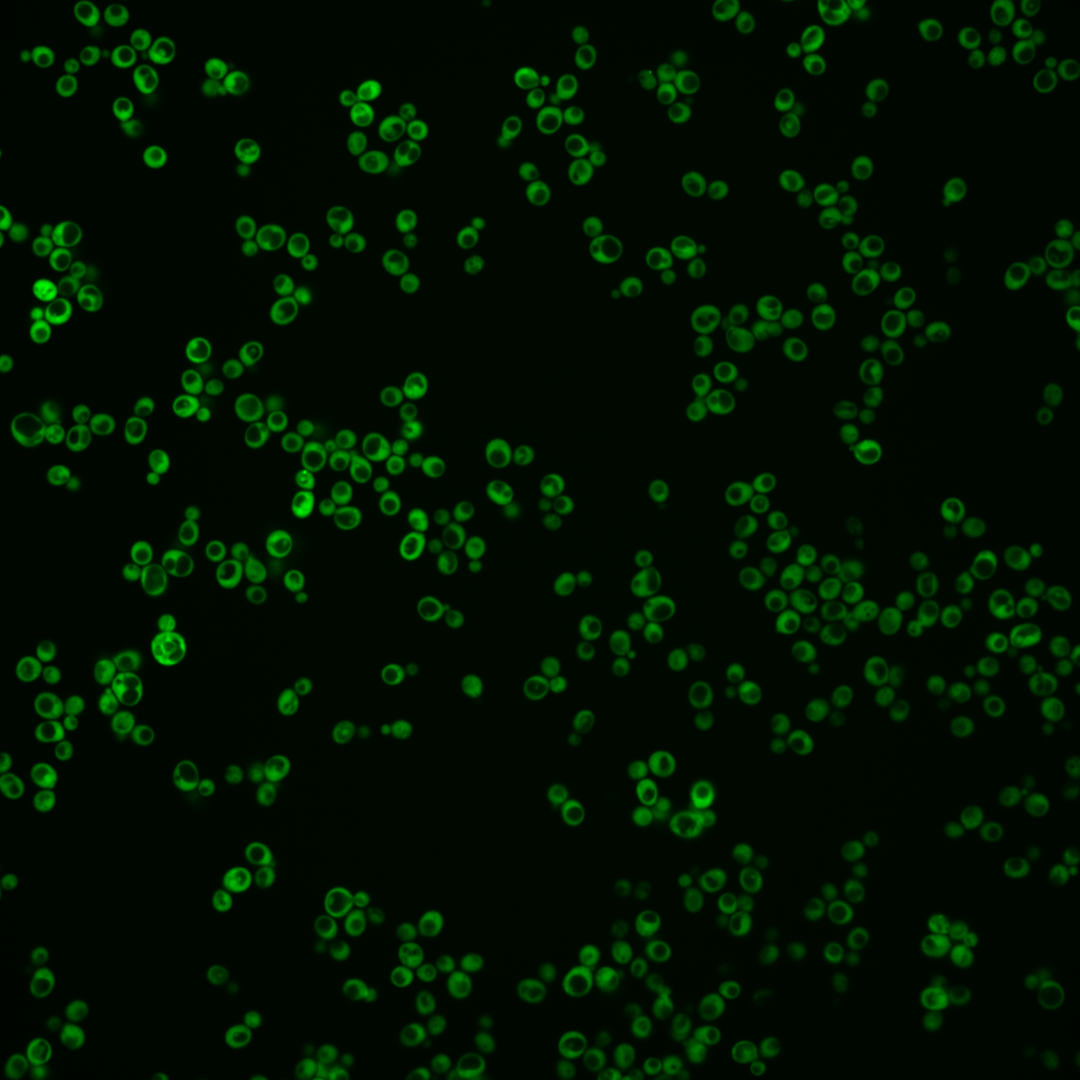
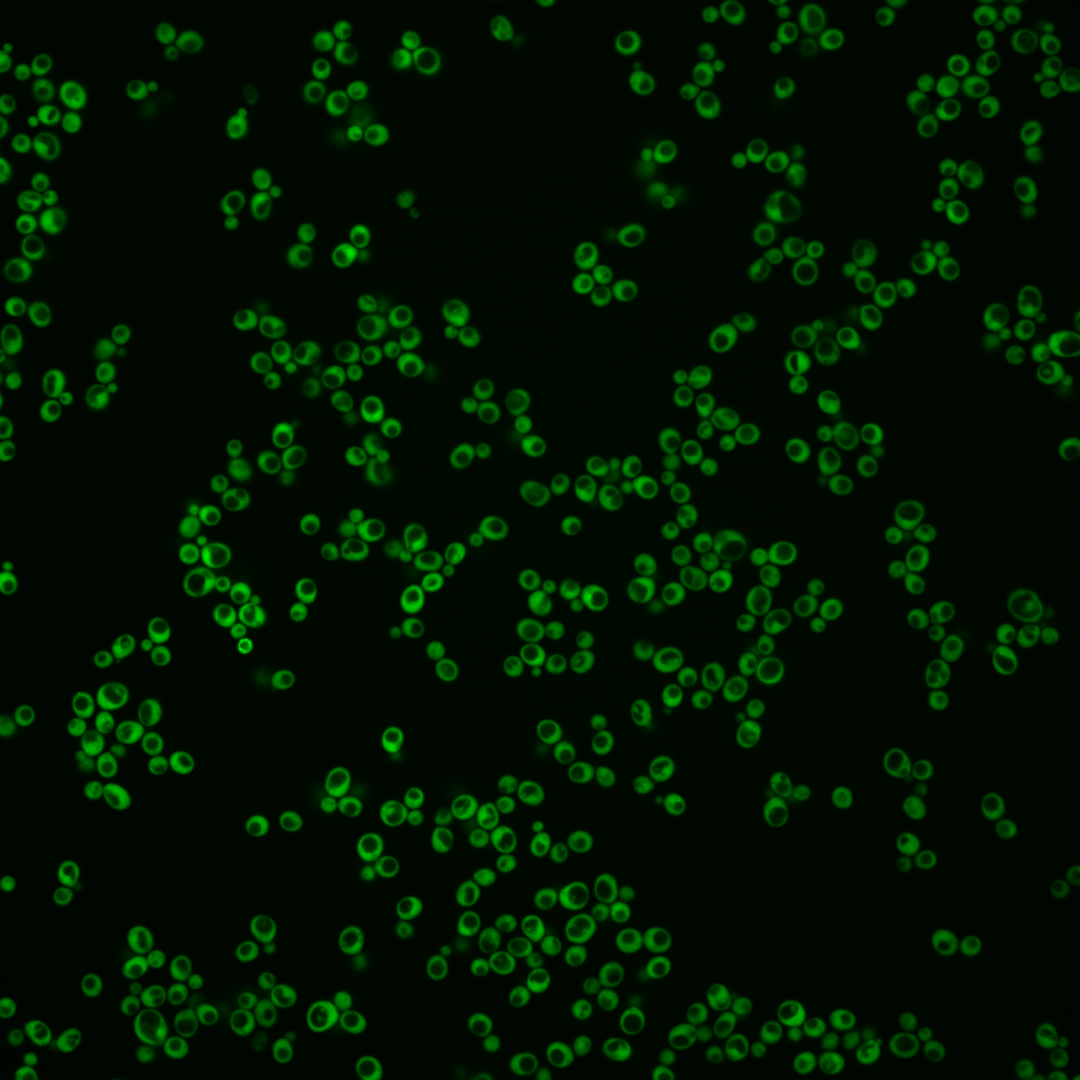

| Standard name | |
|---|---|
| Human Ortholog | |
| Description | Argininosuccinate lyase; catalyzes the final step in the arginine biosynthesis pathway |
Micrographs




















































































Sub-cellular Localization
Yeast GFP Assignment
Protein Abundance
Localization Change
External localization resources
| ensLOC | DeepLoc | |||||||||||||||||||||||
|---|---|---|---|---|---|---|---|---|---|---|---|---|---|---|---|---|---|---|---|---|---|---|---|---|
| Localization | WT1 | WT2 | WT3 | RAP60 | RAP140 | RAP220 | RAP300 | RAP380 | RAP460 | RAP540 | RAP620 | RAP700 | HU80 | HU120 | HU160 | rpd3Δ_1 | rpd3Δ_2 | rpd3Δ_3 | WT1 | WT2 | WT3 | AF100 | AF140 | AF180 |
| Cortical Patches | 0 | 0 | 0 | 0 | 0 | 0 | 2 | 1 | 0 | 2 | 4 | 3 | 0 | 0 | 0 | 0 | 0 | 0 | 1 | 0 | 0 | 0 | 1 | 2 |
| Bud | 0 | 0 | 0 | 0 | 0 | 0 | 0 | 2 | 0 | 0 | 0 | 1 | 0 | 0 | 0 | 0 | 0 | 0 | 1 | 0 | 0 | 1 | 2 | 5 |
| Bud Neck | 0 | 0 | 0 | 0 | 0 | 0 | 0 | 0 | 0 | 0 | 0 | 0 | 0 | 0 | 0 | 0 | 0 | 0 | 0 | 0 | 0 | 0 | 0 | 0 |
| Bud Site | 0 | 0 | 0 | 0 | 0 | 0 | 0 | 0 | 0 | 0 | 0 | 0 | 0 | 0 | 0 | 0 | 0 | 0 | – | – | – | – | – | – |
| Cell Periphery | 0 | 0 | 0 | 0 | 1 | 0 | 3 | 1 | 2 | 3 | 4 | 7 | 0 | 0 | 0 | 0 | 0 | 1 | 0 | 0 | 0 | 0 | 0 | 0 |
| Cytoplasm | 239 | 138 | 27 | 52 | 131 | 146 | 152 | 181 | 107 | 147 | 95 | 138 | 341 | 462 | 567 | 122 | 143 | 113 | 222 | 123 | 56 | 205 | 295 | 292 |
| Endoplasmic Reticulum | 1 | 0 | 1 | 0 | 0 | 2 | 9 | 16 | 9 | 15 | 7 | 7 | 2 | 0 | 2 | 8 | 9 | 3 | 1 | 0 | 0 | 0 | 1 | 15 |
| Endosome | 0 | 0 | 0 | 0 | 0 | 0 | 0 | 0 | 0 | 0 | 0 | 0 | 0 | 0 | 2 | 0 | 0 | 0 | 1 | 0 | 0 | 0 | 0 | 3 |
| Golgi | 1 | 0 | 0 | 0 | 0 | 0 | 0 | 1 | 0 | 1 | 4 | 2 | 0 | 0 | 0 | 2 | 2 | 0 | 0 | 0 | 0 | 0 | 0 | 6 |
| Mitochondria | 0 | 0 | 0 | 1 | 0 | 3 | 1 | 1 | 3 | 5 | 7 | 6 | 0 | 0 | 0 | 0 | 1 | 0 | 0 | 0 | 0 | 0 | 0 | 0 |
| Nucleus | 2 | 0 | 0 | 0 | 0 | 1 | 0 | 1 | 1 | 0 | 0 | 2 | 0 | 0 | 0 | 0 | 0 | 0 | 3 | 2 | 0 | 3 | 3 | 16 |
| Nuclear Periphery | 0 | 0 | 0 | 0 | 0 | 0 | 0 | 0 | 0 | 0 | 0 | 1 | 0 | 0 | 0 | 0 | 0 | 0 | 0 | 0 | 0 | 0 | 0 | 1 |
| Nucleolus | 0 | 0 | 0 | 0 | 0 | 0 | 1 | 2 | 0 | 0 | 0 | 0 | 0 | 0 | 0 | 1 | 2 | 2 | 0 | 0 | 0 | 0 | 0 | 0 |
| Peroxisomes | 0 | 0 | 0 | 0 | 0 | 0 | 0 | 0 | 0 | 0 | 0 | 0 | 0 | 0 | 0 | 0 | 0 | 0 | 0 | 0 | 0 | 0 | 0 | 0 |
| SpindlePole | 0 | 0 | 0 | 0 | 0 | 0 | 0 | 0 | 0 | 0 | 0 | 0 | 0 | 0 | 0 | 0 | 0 | 0 | 0 | 0 | 0 | 0 | 1 | 0 |
| Vac/Vac Membrane | 4 | 0 | 0 | 0 | 0 | 0 | 5 | 7 | 0 | 5 | 5 | 3 | 0 | 2 | 2 | 2 | 1 | 1 | 1 | 3 | 0 | 2 | 5 | 17 |
| Unique Cell Count | 247 | 138 | 28 | 53 | 131 | 151 | 167 | 208 | 119 | 171 | 117 | 165 | 342 | 463 | 573 | 125 | 149 | 115 | 242 | 133 | 60 | 220 | 320 | 373 |
| Labelled Cell Count | 247 | 138 | 28 | 53 | 132 | 152 | 173 | 213 | 122 | 178 | 126 | 170 | 343 | 464 | 573 | 135 | 158 | 120 | 242 | 133 | 60 | 220 | 320 | 373 |
Yeast GFP Assignment
Protein Abundance
| Screen | WT1 | WT2 | WT3 | RAP60 | RAP140 | RAP220 | RAP300 | RAP380 | RAP460 | RAP540 | RAP620 | RAP700 | HU80 | HU120 | HU160 | rpd3Δ_1 | rpd3Δ_2 | rpd3Δ_3 | AF100 | AF140 | AF180 |
|---|---|---|---|---|---|---|---|---|---|---|---|---|---|---|---|---|---|---|---|---|---|
| Mean Cell GFP Intensity (1e-4) | 97.3 | 100.8 | 75.5 | 62.2 | 68.5 | 55.5 | 50.5 | 39.8 | 41.4 | 40.6 | 34.1 | 34.1 | 96.1 | 91.2 | 87.8 | 108.7 | 127.6 | 152.4 | 90.1 | 86.1 | 91.8 |
| Std Deviation (1e-4) | 28.6 | 28.0 | 14.2 | 18.4 | 18.5 | 17.8 | 16.0 | 15.8 | 14.0 | 13.5 | 13.9 | 11.8 | 21.5 | 22.2 | 18.5 | 29.1 | 37.4 | 24.4 | 19.8 | 22.4 | 24.4 |
| Intensity Change (Log2) | – | – | – | -0.28 | -0.14 | -0.44 | -0.58 | -0.93 | -0.87 | -0.9 | -1.15 | -1.15 | 0.35 | 0.27 | 0.22 | 0.52 | 0.76 | 1.01 | 0.25 | 0.19 | 0.28 |
Localization Change
| Localization | RAP60 | RAP140 | RAP220 | RAP300 | RAP380 | RAP460 | RAP540 | RAP620 | RAP700 | HU80 | HU120 | HU160 | rpd3Δ_1 | rpd3Δ_2 | rpd3Δ_3 |
|---|---|---|---|---|---|---|---|---|---|---|---|---|---|---|---|
| Cortical Patches | 0 | 0 | 0 | 0 | 0 | 0 | 0 | 0 | 0 | 0 | 0 | 0 | 0 | 0 | 0 |
| Bud | 0 | 0 | 0 | 0 | 0 | 0 | 0 | 0 | 0 | 0 | 0 | 0 | 0 | 0 | 0 |
| Bud Neck | 0 | 0 | 0 | 0 | 0 | 0 | 0 | 0 | 0 | 0 | 0 | 0 | 0 | 0 | 0 |
| Bud Site | 0 | 0 | 0 | 0 | 0 | 0 | 0 | 0 | 0 | 0 | 0 | 0 | 0 | 0 | 0 |
| Cell Periphery | 0 | 0 | 0 | 0 | 0 | 0 | 0 | 0 | 0 | 0 | 0 | 0 | 0 | 0 | 0 |
| Cytoplasm | 0.5 | 2.2 | 0.1 | -1.0 | -1.4 | -1.1 | -1.5 | -2.0 | -1.8 | 2.3 | 2.7 | 1.2 | 0.4 | -0.1 | 0.6 |
| Endoplasmic Reticulum | 0 | 0 | 0 | 0 | 0 | 0 | 0 | 0 | 0 | 0 | 0 | 0 | 0 | 0 | 0 |
| Endosome | 0 | 0 | 0 | 0 | 0 | 0 | 0 | 0 | 0 | 0 | 0 | 0 | 0 | 0 | 0 |
| Golgi | 0 | 0 | 0 | 0 | 0 | 0 | 0 | 0 | 0 | 0 | 0 | 0 | 0 | 0 | 0 |
| Mitochondria | 0 | 0 | 0 | 0 | 0 | 0 | 0 | 0 | 0 | 0 | 0 | 0 | 0 | 0 | 0 |
| Nucleus | 0 | 0 | 0 | 0 | 0 | 0 | 0 | 0 | 0 | 0 | 0 | 0 | 0 | 0 | 0 |
| Nuclear Periphery | 0 | 0 | 0 | 0 | 0 | 0 | 0 | 0 | 0 | 0 | 0 | 0 | 0 | 0 | 0 |
| Nucleolus | 0 | 0 | 0 | 0 | 0 | 0 | 0 | 0 | 0 | 0 | 0 | 0 | 0 | 0 | 0 |
| Peroxisomes | 0 | 0 | 0 | 0 | 0 | 0 | 0 | 0 | 0 | 0 | 0 | 0 | 0 | 0 | 0 |
| SpindlePole | 0 | 0 | 0 | 0 | 0 | 0 | 0 | 0 | 0 | 0 | 0 | 0 | 0 | 0 | 0 |
| Vacuole | 0 | 0 | 0 | 0 | 0 | 0 | 0 | 0 | 0 | 0 | 0 | 0 | 0 | 0 | 0 |
External localization resources
Images






























Protein Concentration and Protein Localization Data
| R1 | R2 | R3 | ||||||||||||||||
|---|---|---|---|---|---|---|---|---|---|---|---|---|---|---|---|---|---|---|
| G1 Pre-START | G1 Post-START | S/G2 | Metaphase | Anaphase | Telophase | G1 Pre-START | G1 Post-START | S/G2 | Metaphase | Anaphase | Telophase | G1 Pre-START | G1 Post-START | S/G2 | Metaphase | Anaphase | Telophase | |
| Concentration | 155.1946 | 198.7815 | 168.8263 | 170.8355 | 174.6779 | 165.4175 | 105.1144 | 146.4622 | 138.2431 | 117.9642 | 91.4621 | 129.7322 | 151.3499 | 183.9711 | 170.2898 | 170.4221 | 174.1193 | 152.9056 |
| Actin | 0.0103 | 0.0001 | 0.0024 | 0.0001 | 0.0001 | 0.0006 | 0.0062 | 0.0004 | 0.0009 | 0.0314 | 0.0025 | 0.0092 | 0.0003 | 0.0001 | 0.0038 | 0.0091 | 0.0001 | 0.0007 |
| Bud | 0.0008 | 0.0001 | 0.0003 | 0 | 0.0004 | 0.0004 | 0.0005 | 0.0001 | 0.0019 | 0.0004 | 0.0043 | 0.0003 | 0.001 | 0.0001 | 0.0003 | 0.0003 | 0.0001 | 0.0002 |
| Bud Neck | 0.0007 | 0.0002 | 0.0017 | 0.0002 | 0.0003 | 0.001 | 0.0003 | 0.0001 | 0.0002 | 0.0002 | 0.0004 | 0.0008 | 0.0002 | 0.0001 | 0.0002 | 0.0002 | 0.0002 | 0.0014 |
| Bud Periphery | 0.0006 | 0 | 0.0003 | 0 | 0.0001 | 0.0001 | 0.0002 | 0 | 0.0006 | 0.0002 | 0.0008 | 0.0001 | 0.0004 | 0 | 0.0002 | 0.0002 | 0 | 0 |
| Bud Site | 0.0003 | 0.0001 | 0.005 | 0 | 0.0001 | 0 | 0.0009 | 0.0004 | 0.0002 | 0.0001 | 0.0004 | 0.0003 | 0.0001 | 0 | 0.0016 | 0.0009 | 0 | 0 |
| Cell Periphery | 0.0007 | 0.0015 | 0.0008 | 0.0002 | 0.0003 | 0.0003 | 0.0004 | 0 | 0.0003 | 0.0001 | 0.0001 | 0.0001 | 0.0001 | 0.0001 | 0.0002 | 0.0003 | 0 | 0.0002 |
| Cytoplasm | 0.8292 | 0.973 | 0.8993 | 0.9099 | 0.9163 | 0.8538 | 0.8002 | 0.9915 | 0.9692 | 0.876 | 0.6895 | 0.9098 | 0.9121 | 0.9772 | 0.919 | 0.867 | 0.9761 | 0.9428 |
| Cytoplasmic Foci | 0.0062 | 0.0001 | 0.0071 | 0.0001 | 0.0006 | 0.0005 | 0.0051 | 0.0001 | 0.0016 | 0.0004 | 0.0015 | 0.0013 | 0.0052 | 0.0001 | 0.0146 | 0.0282 | 0.0001 | 0.0004 |
| Eisosomes | 0.0008 | 0 | 0.0002 | 0 | 0 | 0 | 0.0003 | 0 | 0 | 0.0001 | 0 | 0.0001 | 0 | 0 | 0.0001 | 0.0011 | 0 | 0 |
| Endoplasmic Reticulum | 0.001 | 0.0001 | 0.0002 | 0.0001 | 0.0001 | 0.0004 | 0.0021 | 0.0001 | 0.0001 | 0.0043 | 0.0005 | 0.0057 | 0.0002 | 0.0001 | 0.0006 | 0.0005 | 0.0001 | 0.0003 |
| Endosome | 0.0021 | 0 | 0.0029 | 0 | 0.0004 | 0.0002 | 0.0019 | 0 | 0.0003 | 0.0035 | 0.0007 | 0.0103 | 0.0002 | 0 | 0.0028 | 0.0031 | 0 | 0.0001 |
| Golgi | 0.0007 | 0 | 0.0013 | 0 | 0 | 0 | 0.0008 | 0 | 0 | 0.0012 | 0 | 0.0007 | 0 | 0 | 0.001 | 0.0025 | 0 | 0 |
| Lipid Particles | 0.0026 | 0 | 0.0058 | 0 | 0 | 0.0001 | 0.0022 | 0 | 0.0001 | 0.0001 | 0 | 0.0005 | 0.0006 | 0 | 0.0033 | 0.015 | 0 | 0.0001 |
| Mitochondria | 0.0056 | 0.0003 | 0.0036 | 0.0003 | 0.003 | 0.001 | 0.0044 | 0.0001 | 0.0034 | 0.0031 | 0.0587 | 0.0013 | 0.0016 | 0.0003 | 0.0041 | 0.0169 | 0.0001 | 0.0002 |
| None | 0.0181 | 0.0002 | 0.0026 | 0.0003 | 0.0005 | 0.0012 | 0.0044 | 0.0001 | 0.0017 | 0.0008 | 0.0057 | 0.006 | 0.0026 | 0.0006 | 0.0044 | 0.024 | 0.0002 | 0.0004 |
| Nuclear Periphery | 0.0138 | 0.0034 | 0.0067 | 0.014 | 0.0098 | 0.0239 | 0.0284 | 0.0009 | 0.0015 | 0.0224 | 0.0407 | 0.0218 | 0.0072 | 0.0019 | 0.0037 | 0.0019 | 0.0033 | 0.0123 |
| Nucleolus | 0.0053 | 0.0003 | 0.0063 | 0.0005 | 0.0014 | 0.0024 | 0.0052 | 0 | 0.0008 | 0.0002 | 0.0016 | 0.0005 | 0.0047 | 0.0005 | 0.0028 | 0.0077 | 0 | 0.0003 |
| Nucleus | 0.0896 | 0.0185 | 0.0337 | 0.0719 | 0.0496 | 0.1083 | 0.1243 | 0.0058 | 0.0128 | 0.0533 | 0.1847 | 0.0227 | 0.0604 | 0.0179 | 0.031 | 0.0132 | 0.019 | 0.0388 |
| Peroxisomes | 0.001 | 0 | 0.0137 | 0 | 0.0001 | 0 | 0.0003 | 0 | 0.0002 | 0.0001 | 0.0006 | 0.0002 | 0.0001 | 0 | 0.0012 | 0.0034 | 0 | 0 |
| Punctate Nuclear | 0.0063 | 0.0001 | 0.003 | 0.0002 | 0.0002 | 0.001 | 0.0072 | 0.0001 | 0.0001 | 0.0005 | 0.0012 | 0.0066 | 0.0007 | 0.0001 | 0.0026 | 0.0012 | 0.0001 | 0.0007 |
| Vacuole | 0.0026 | 0.0017 | 0.0019 | 0.0011 | 0.0078 | 0.0026 | 0.0023 | 0.0001 | 0.0031 | 0.0006 | 0.0021 | 0.0009 | 0.0015 | 0.0005 | 0.0016 | 0.0014 | 0.0003 | 0.0007 |
| Vacuole Periphery | 0.0018 | 0.0004 | 0.0012 | 0.0011 | 0.0089 | 0.0022 | 0.0026 | 0 | 0.001 | 0.0012 | 0.0037 | 0.0007 | 0.0007 | 0.0004 | 0.001 | 0.0017 | 0.0003 | 0.0004 |
Sequencing Data
| R1 | R2 | |||||||||
|---|---|---|---|---|---|---|---|---|---|---|
| G1 Post-START | S/G2 | Metaphase | Anaphase | Telophase | G1 Post-START | S/G2 | Metaphase | Anaphase | Telophase | |
| Gene Expression | 49.9386 | 46.0592 | 51.004 | 69.9686 | 61.1504 | 96.6529 | 97.7979 | 102.2746 | 107.5303 | 84.3273 |
| Translational Efficiency | 1.9473 | 1.9608 | 1.5951 | 1.7039 | 1.8667 | 1.5011 | 1.5254 | 1.4217 | 1.4677 | 1.5718 |
Hit Data
| Dataset | Hit |
|---|---|
| Protein Concentration | ✘ |
| Protein Localization | ✘ |
| Gene Expression | ✘ |
| Translational Efficiency | ✘ |
Endocytosis
| Temp | Actin Patch (Sac6-tdTomato) | Cortical Patch (Sla1-GFP) | Late Endosome (Snf7-GFP) | Vacuole (Vph1-GFP) |
|---|---|---|---|---|
| 37℃ | ||||
| RT |
Cell Cycle Omics
CYCLoPs (Arg4-GFP)
| Gene / Allele | Actin Patch (Sac6-tdTomato) | Cortical Patch (Sla1-GFP) | Late Endosome (Snf7-GFP) | Vacuole (Sac6-tdTomato) |
|---|
| Gene | Images |
|---|
| Gene | Images |
|---|
Images are not yet available
Images are not yet available